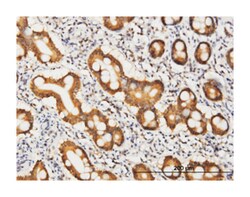
Coenzyme A synthase, Mouse, Clone: 2A12, Abnova 100&mu;g; Unlabeled:Antibodies,

Learn More
Coenzyme A synthase, Mouse, Clone: 2A12, Abnova™
Mouse monoclonal antibody raised against a partial recombinant COASY.
Brand: Abnova H00080347-M05.100ug
Description
Biosynthesis of coenzyme A (CoA) from pantothenic acid (vitamin B5) is an essential universal pathway in prokaryotes and eukaryotes. COASY is a bifunctional enzyme that catalyzes the 2 last steps in CoA synthesis. These activities are performed by 2 separate enzymes, phosphopantetheine adenylyltransferase (PPAT; EC 2.7.7.3) and dephospho-CoA kinase (DPCK; EC 2.7.1.24), in prokaryotes (Daugherty et al., 2002 [PubMed 11923312]).[supplied by OMIM
Sequence: AEGKRVCVIDAAVLLEAGWQNLVHEVWTAVIPETEAVRRIVERDGLSEAAAQSRLQSQMSGQQLVEQSHVVLSTLWEPHITQRQVEKAWALLQKRIPKTHQALDSpecifications
| Coenzyme A synthase | |
| Monoclonal | |
| Unconjugated | |
| PBS with no preservative; pH 7.4 | |
| NM_025233 | |
| COASY | |
| COASY (NP_079509, 461 a.a. ∼ 564 a.a) partial recombinant protein with GST tag. MW of the GST tag alone is 26 KDa. | |
| 100 μg | |
| Yes | |
| 80347 | |
| Store at -20°C or lower. Aliquot to avoid repeated freezing and thawing. | |
| IgG1 κ |
| ELISA, Immunohistochemistry (PFA fixed), Western Blot | |
| 2A12 | |
| Mouse monoclonal antibody raised against a partial recombinant COASY. | |
| COASY | |
| DPCK/FLJ35179/NBP/PPAT/UKR1/pOV-2 | |
| Mouse | |
| Affinity Purified | |
| RUO | |
| Primary | |
| Human | |
| Antibody |
Your input is important to us. Please complete this form to provide feedback related to the content on this product.